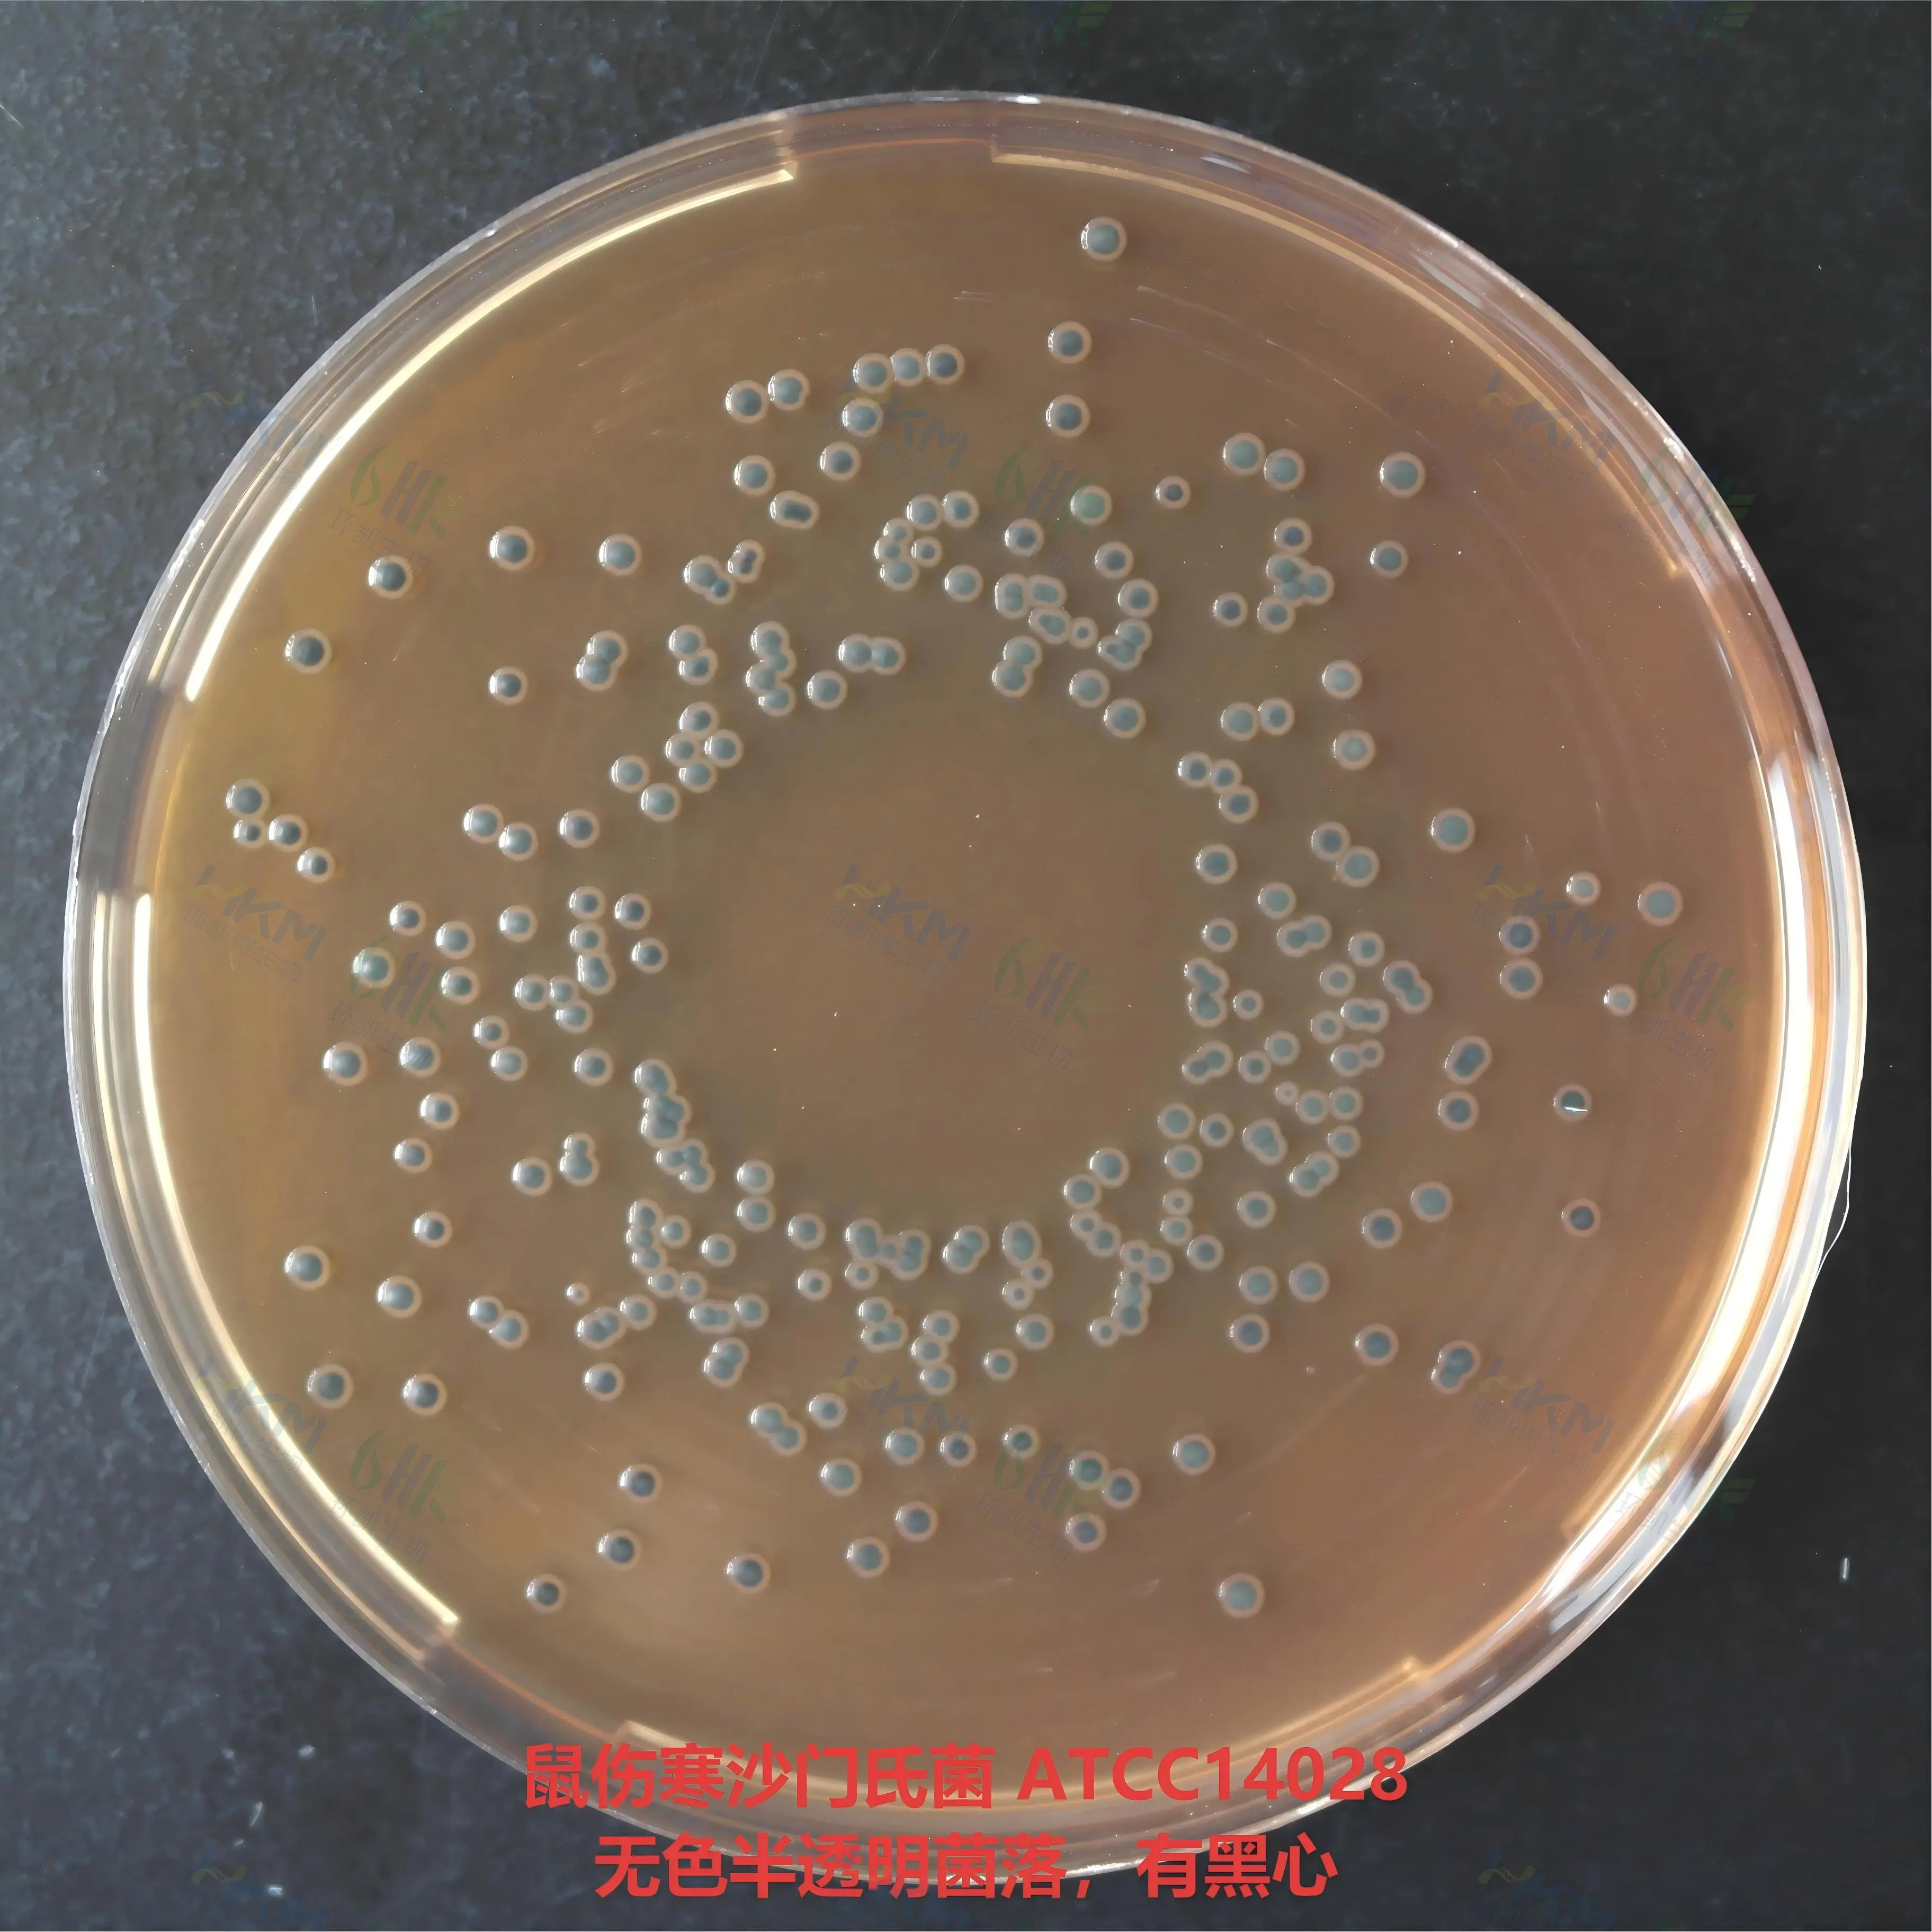
DHL琼脂(胆硫乳琼脂)培养基质量控制

商品详细
说明书
微生物图册
行业应用
相关论文
通用名称:DHL琼脂(胆硫乳琼脂)
英文名称:Deoxycholate Hydrogen Sulfide Lactose Agar
通常叫法:胆硫乳琼脂培养基 | DHL琼脂培养基
产品编号与包装规格:
| 产品编号 | 产品类型 | 包装规格 |
|---|---|---|
| 023060 | 干粉 | 250g/瓶 |
产品用途:用于肠道致病菌特别是沙门氏菌和志贺氏菌的选择性分离培养。
检验原理:蛋白胨、牛肉膏粉提供碳源、氮源、维生素和矿物质;乳糖、蔗糖为可发酵的糖类;去氧胆酸钠和柠檬酸钠抑制革兰氏阳性菌及大多数的大肠菌群和变形杆菌,但不影响沙门氏菌的生长;硫代硫酸钠和柠檬酸铁铵用于检测硫化氢的产生,使菌落中心呈黑色;中性红为pH指示剂,发酵糖产酸的菌落呈红色,不发酵糖的菌落为无色;琼脂是培养基的凝固剂。
DHL琼脂(胆硫乳琼脂)培养基配方成分:
| 配方 | 含量(每升) |
|---|---|
| 蛋白胨 | 20.0g |
| 牛肉膏粉 | 3.0g |
| 乳糖 | 10.0g |
| 蔗糖 | 10.0g |
| 去氧胆酸钠 | 1.0g |
| 硫代硫酸钠 | 2.3g |
| 柠檬酸钠 | 1.0g |
| 柠檬酸铁铵 | 1.0g |
| 中性红 | 0.03g |
| 琼脂 | 15.0g |
| 最终pH 7.3±0.2 | |
使用方法:称取本品63.3g,加入蒸馏水或去离子水1 L,搅拌加热煮沸至完全溶解,不需高压蒸汽灭菌,待冷至50℃左右,倾注灭菌平皿,待凝固后,备用。
DHL琼脂(胆硫乳琼脂)培养基质量控制【下列质控菌株接种待测试培养基, 35~37℃,24h结果如下:】
| 指标 | 质控菌株及编号 | 标准值 | 特征性反应 |
|---|---|---|---|
| 生长率 | 鼠伤寒沙门氏菌ATCC14028 | PR≥0.5 | 无色半透明菌落,有黑心 |
| 福氏志贺氏菌CMCC(B)51572 | PR≥0.5 | 无色至淡红色菌落,半透明 | |
| 特异性 | 大肠埃希氏菌ATCC25922 | — | 粉红色菌落,有胆酸沉淀 |
| 选择性 | 粪肠球菌ATCC29212 | G≤1 | — |
储存条件与保质期:贮存于避光、干燥处,用后立即旋紧瓶盖;贮存期三年。
参考文献:
1、SN0170-92 中华人民共和国进出口商品检验行业标准 出口食品中沙门氏菌属(包括亚利桑那菌)检验方法
2、SN/T 2206.1-2008中华人民共和国进出口商品检验行业标准 化妆品微生物检验方法 第1部分:沙门氏菌
3、GB 13091-2018 中华人民共和国国家标准 饲料中沙门氏菌的检验方法
DHL琼脂(胆硫乳琼脂)培养基 相关产品(用于沙门氏菌检验):
| 产品名称 | 产品货号 | 产品类型 | 规格 | 产品说明及用途 |
| dhl琼脂平板 | 023065 | 成品平板 | 90mm×20个 | 用于肠道致病菌特别是沙门氏菌和志贺氏菌的选择性分离培养(GB) |
| HE琼脂培养基 | 023070 | 干粉 | 250g/瓶 | 用于肠道致病菌特别是沙门氏菌和志贺氏菌的选择性分离培养(GB4789.4和SN/T220) |
| HE琼脂颗粒培养基 | 023070P1 | 颗粒 | 250g/瓶 | |
| HE琼脂平板 | CP0110 | 成品平板 | 90mm×20个 | |
| SS琼脂培养基 | 023080 | 干粉 | 250g/瓶 | 用于沙门氏菌和某些志贺氏菌的选择性分离培养。(SN/T2206.1) |
| SS琼脂平板培养基 | 024077 | 成品平板 | 90mm×20个 | |
| 酚红煌绿琼脂 | 023110 | 干粉 | 250g/瓶 | 用于分离培养沙门氏菌(伤寒沙门氏菌除外)。(GB13091-91) |
| 中国蓝琼脂培养基 | 023115 | 干粉 | 250g/瓶 | 用于肠道菌的弱选择性分离培养。 |
| 中国蓝琼脂平板 | CP0090 | 成品平板 | 90mm×20个 | |
| 中国蓝琼脂培养基(红色配方) | 023115T2 | 干粉 | 250g/瓶 | 用于肠道菌的弱选择性分离。 |
| 沙门氏菌鞭毛诱导软琼脂 | 023118 | 干粉 | 250g/瓶 | 用于沙门氏菌鞭毛的诱导。 |
| 三糖铁(TSI)琼脂培养基 | 022080 | 干粉 | 250g/瓶 | 用于鉴别肠道菌发酵蔗糖、乳糖、葡萄糖及产生硫化氢的生化反应。(GB4789.4) |
| 三糖铁琼脂斜面(TSI) | CP0080 | 管装成品 | 10mL×20支 | |
| 沙门氏菌显色培养基 | CRM004 | 干粉 | 1000mL/瓶 | 用于沙门氏菌的分离和初步鉴定 |
| 沙门氏菌显色培养基平板 | CP0560 | 成品平板 | 90mm×20个 | |
| EasyID沙门氏菌生化鉴定试剂盒 | HKI002 | 试剂盒 | 11项×10套 | 用于沙门氏菌13项生化反应 |
| 沙门氏菌核酸检测试剂盒(PCR-荧光探针法) | FZ005BF2 | 分子试剂盒 | 48test | 用于食品中沙门氏菌的检测 |
| RV沙门菌增菌液体培养基(中国药典) | 023022 | 干粉 | 250g/瓶 | 用于沙门氏菌选择性增菌培养。(ChP、USP) |
| RV沙门菌增菌液体培养基(颗粒型)(中国药典) | 023022P1 | 颗粒 | 250g/瓶 | |
| RV沙门菌增菌液体培养基(管装成品)(中国药典) | CP3022G1 | 管装成品 | 10mL×20支 | |
| 木糖赖氨酸脱氧胆酸盐琼脂培养基(中国药典) | 029997 | 干粉 | 250g/瓶 | 用于药品中沙门氏菌的选择分离培养。(中国药典) |
| XLD琼脂培养基(颗粒性)(中国药典) | 029997P1 | 颗粒 | 250g/瓶 | |
| XLD琼脂平板培养基(中国药典) | CP9997B1 | 成品平板 | 90mm×10个 | |
| 三糖铁琼脂培养基(TSI)(药典) | 022081 | 干粉 | 250g/瓶 | 用于鉴别肠道菌发酵蔗糖、乳糖、葡萄糖及产生硫化氢的生化反应。(药典) |
| 三糖铁琼脂颗粒型培养基(药典) | 022081P1 | 颗粒 | 250g/瓶 | |
| 三糖铁琼脂斜面培养基(TSI)(药典) | CP22081G1 | 管装成品 | 10mL×20支 | |
| 沙门、志贺菌属琼脂培养基(SS)(药典) | 023081 | 干粉 | 250g/瓶 | 用于沙门氏菌和某些志贺氏菌的选择性分离培养。(《中华人民共和国药典》) |
| 胆盐硫乳琼脂培养基(DHL)(药典) | 023062 | 干粉 | 250g/瓶 | 用于肠道致病菌特别是沙门氏菌和志贺氏菌的选择性分离培养(药典) |
| 缓冲蛋白胨水(BPW) | 023130 | 干粉 | 250g/瓶 | 用于食品中沙门氏菌和阪崎肠杆菌的前增菌培养。(GB 4789.4、GB 4789.40) |
| 缓冲蛋白胨水瓶装颗粒培养基(BPW) | 023130P1 | 颗粒 | 250g/瓶 | |
| 缓冲蛋白胨水(BPW)(225mL袋装) | CP0680 | 袋装成品 | 225mL×10袋 | |
| 缓冲蛋白胨水(BPW)(225mL瓶装) | CP0290 | 瓶装液体 | 225mL×10瓶 | |
| 缓冲蛋白胨水(BPW)(管装成品) | CP0560A | 管装成品 | 9mL×20支 | |
| 氯化镁孔雀绿增菌液(MM) | 023020 | 干粉 | 250g/瓶 | 用于食品和环境样本中沙门氏菌的选择性增菌培养。 |
| 乳糖肉汤(LB)培养基 | 023137 | 干粉 | 250g/瓶 | 用于沙门氏菌前增菌培养。(FDA) |
| GN增菌液 | 023140 | 干粉 | 250g/瓶 | 用于革兰氏阴性菌的选择性培养,特别是志贺氏菌和沙门氏菌的增菌培养(GB/T4789.5、GB/T4789.28) |
| GN增菌液(管装成品) | 23140G1 | 管装成品 | 10mL×20支 | |
| GN增菌液 | CP0550 | 瓶装液体 | 225mL×10瓶 | |
| GN增菌液 | CP0650 | 袋装成品 | 225mL×10袋 | |
| 双料GN增菌液 | C23140P2 | 瓶装液体 | 100mL/瓶 | |
| 亚硒酸盐增菌液(SF) | 023041 | 干粉 | 100g/瓶 | 用于污水和污泥中沙门氏菌的选择性增菌。(GB18466) |
| SF增菌液(10mL管装成品) | CP0330A | 管装成品 | 10mL×20支 | |
| 双料亚硒酸盐增菌液(SF) | C23041P1 | 瓶装液体 | 100mL/瓶 | |
| 亚硒酸盐胱氨酸增菌液(SC) | 023040 | 干粉 | 250g/瓶 | 用于沙门氏菌选择性增菌培养。(GB 4789.4) |
| 亚硒酸盐胱氨酸增菌颗粒性培养基(SC) | 023040P1 | 颗粒 | 250g/瓶 | |
| SC增菌液(10mL管装成品) | CP0050 | 管装成品 | 10mL×20支 | |
| 四硫磺酸钠煌绿增菌液基础(TTB) | 023030 | 干粉基础 | 250g/瓶 | 用于沙门氏菌选择性增菌培养。(GB 4789.4) |
| 四硫磺酸盐煌绿增菌液(TTB) | 023030B | 瓶装液体 | 250mL/瓶 | |
| 四硫磺酸盐煌绿增菌液(TTB) | CP0300 | 管装成品 | 10mL×20支 | |
| Muller-Kauffmann氏四硫磺酸钠肉汤基础 | 023032 | 干粉基础 | 250g/瓶 | 用于羽绒羽毛中沙门氏菌选择性培养 |
| 改良亚硒酸盐磺绿增菌肉汤培养基(SBG增菌液) | 023043 | 干粉 | 250g/瓶 | 用于沙门氏菌选择性增菌培养。 |
| SBG增菌液(5mL管装成品) | CP0810G | 管装成品 | 5mL×20支 | |
| MKTTn肉汤基础培养基 | 023033 | 干粉基础 | 250g/瓶 | 用于沙门氏菌选择性增菌培养。(ISO) |
| MKTTn肉汤培养基(ISO) | C23033G1 | 管装成品 | 10mL×20支 | |
| 改良MSRV培养基琼脂基础(半固体) | 023025 | 干粉基础 | 250g/瓶 | 用于分离游动性沙门氏菌 (Merck方法) |
| XLT-4琼脂基础 | 029996 | 干粉基础 | 250g/瓶 | 用于非伤寒沙门氏菌的选择性分离培养。 |
| XLT-4琼脂平板 | CP0180B | 成品平板 | 90mm×20个 | |
| 亚硫酸铋(BS)琼脂培养基 | 023052 | 干粉 | 250g/瓶 | 用于沙门氏菌特别是伤寒沙门氏菌的选择性分离培养(GB4789.4) |
| BS琼脂平板(保质期1个月) | 022547C | 成品平板 | 90mm×20个 | |
| 木糖赖氨酸去氧胆酸盐(XLD)琼脂培养基 | 029999 | 干粉 | 干粉 | 用于沙门氏菌、志贺氏菌的分离培养。(GB4789.4) |
| 木糖赖氨酸去氧胆酸盐(XLD)琼脂颗粒 | 029999P1 | 颗粒 | 颗粒 | |
| XLD琼脂培养基平板(GB4789.4沙门氏菌检验) | CP0180 | 成品平板 | 90mm×20个 | |
| 木糖赖氨酸去氧胆酸盐(XLD)琼脂(袋装成品) | 029999P | 袋装成品 | 300mL×10袋 |
















